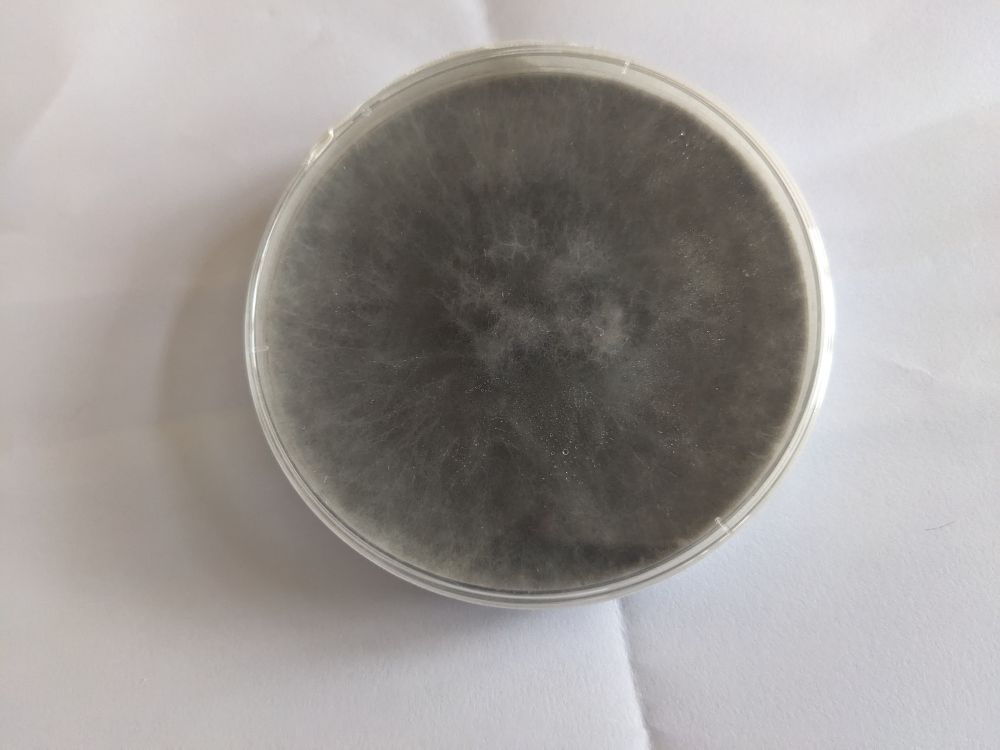
Post image

Congratulations 🎉, You have a nice Farm , can I join your farm plz 🤠
20.09.2025 10:05 — 👍 0 🔁 0 💬 0 📌 0


Working on Isolating alternaria species that cause alternaria leaf spot in cotton
#Tanzania
19.09.2025 10:43 — 👍 2 🔁 0 💬 0 📌 0
Congratulations 🎉
19.09.2025 10:40 — 👍 0 🔁 0 💬 0 📌 0
First in business worldwide. 💰
Itinerant biologist. Most recently working with photosynthetic critters.
Ertegun House is home to the Ertegun Graduate Scholarship Programme in the Humanities at the University of Oxford, and to a range of events in the humanistic disciplines
Science practitioner |
Plant genomics | Breeding | Physiology | Vitamin B metabolism | Ethnobiology & Nutrition | Biodiversity | Climate change | Environment | Youth empowerment
https://www.researchgate.net/profile/Fardous-Mohammad-Azam?ev=prf_overview
🌿 Ph.D. in Plant pathology | 🍄 Mycology | Rust Fungi |🔬 fungal biodiversity, biocontrol & sustainable plant health | 📍Netherlands 🇳🇱
🔗 https://www.linkedin.com/in/paula-gomez-zapata-6418a06b/
Ecologist studying plant microbiota assembly and microbiome engineering / Seeds / SynComs 🦠/ Sustainable agriculture 🌾
Researcher at INRAE, France
http://mariesimonin.com/
plant-microbe interaction scientist @inrae-france.bsky.social working in #France #Toulouse, Deputy director of @lipme-toulouse.bsky.social, Candidate director of @tps-institute.bsky.social, born at 329ppm CO2.
Plant Biologist @LIPME Toulouse & Chargé de
Recherche @INRAE | Genome plasticity, chromatin biology & epigenetics in plant-microbe symbioses | He/Him
Lecturer @AgroParisTech
Exploring/Teaching plant microbiota wonders
Roots - Endophytes - Environment - Omics
I’m 2nd year pHD student working on the roles of long non coding RNA in nitrogen fixing symbiosis in model leguminous plant Medicago truncatula.
LIPME - INRAE - Toulouse
Researching the diversity and interaction of phages with plant pathogenic bacteria 🌱🔬 | INRAE | PHIM | Montpellier, France. 🇵🇸
🇲🇫 Postdoc at the University of Lausanne 🇨🇭
Plant-Microbiota-Pathogen interactions | Bacterial Ecology | Microfluidics | Single-cell imaging | Systems biology
https://julienluneau.com
Junior Group Leader (CR CNRS) @ECOGEN team, LIPME, Toulouse
Former PostDoc @ECOGEN team, LIPME, Toulouse; PostDoc and PhD @MPIPZ, Cologne
Director of Research, CNRS | Microbial Ecologist | incoming EIC for American Society for Microbiology journal #mSystems | ERC #MicroRescue
50% Plant Physiology Lecturer at University of Toulouse, France.
50% Researcher in Plant-Microbe interactions.
50% Parent.
PhD student @lipme-toulouse.bsky.social working on the coordination between endosymbioses and the root endodermis.
Postdoctoral Researcher in Plant-Microbe Interactions and Nematology 🪱 at Aarhus University
Be nice and eat bread 🥖
Post doc at the Max Planck Institute for Plant Breeding Research 🌱
Hacquard’s group. Cologne 🇩🇪
Molecular microbiology assistant-professor at University of Lyon. I tweet only about Science here.
I work on Pectobacteriaceae. I don't like bacteria that can't be genetically manipulated.
Lab website: https://sites.google.com/view/mtsb
👩🔬Microbiology post doc fellow at IRSD 🔬Research in bacterial membrane vesicles and their roles in host-bacteria interactions 🦠 Member of the young microbiologists section of the SFM (the French Microbiology Society)